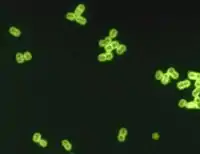

Диплококи
Диплококи — сферичні бактерії (коки) що звичайно зустрічаються парами з двох зв'язаних клітин. Приклади: Streptococcus pneumoniae, Neisseria gonorrhoeae та Neisseria meningitidis.
Диплококи Streptococcus pneumoniae під мікроскопом; видні подвійні бактеріальні клітини
Раніше визнавали рід Diplococcus, але в другій половині XX століття його перейменували на Streptococcus. Рід назвали за морфологією подвійних клітин, хоча вже на той час були відомі диплококи, що не входили до роду.[1]
Примітки
- Robert I Krasner; Teri Shors (9 січня 2013). The Microbial Challenge. Jones & Bartlett Publishers. с. 75. ISBN 978-1-4496-7333-8.(англ.)
This article is issued from Wikipedia. The text is licensed under Creative Commons - Attribution - Sharealike. Additional terms may apply for the media files.